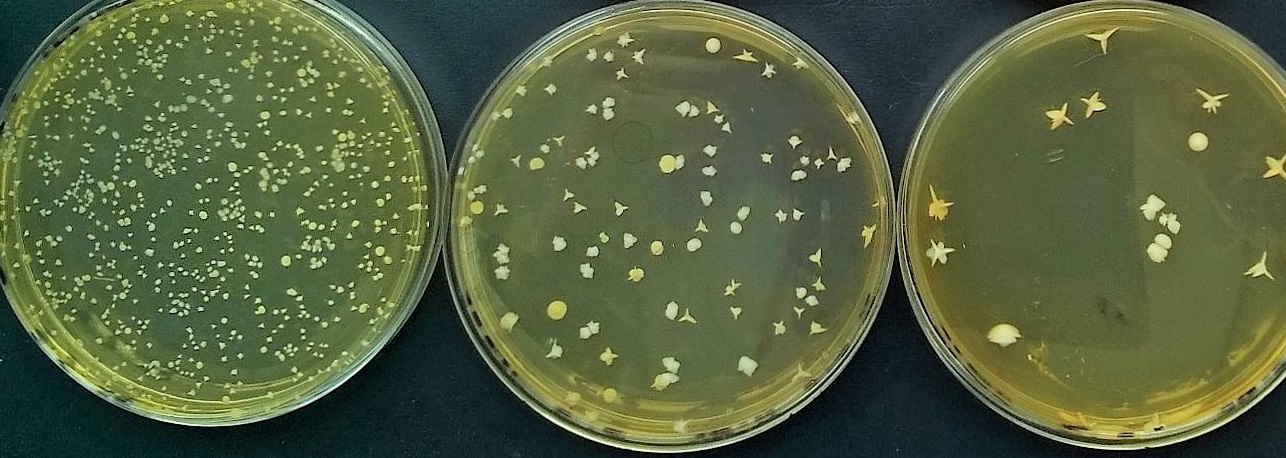

L'eau est indissociable de
la vie des populations humaines. Elle
est aussi malheureusement un des principaux vecteurs de la transmission des
maladies, par l'intermédiaire des germes infectieux, et par voie de conséquence
de la mortalité humaine. Des outils d’évaluation des risques de contamination, ainsi que les
options possibles pour l’atténuation des impacts ou pour la remédiassions de la
contamination des eaux doivent être donc maîtrisés. Les référentiels, les
normes et les méthodes d’analyses des eaux doivent être connus.
- Enseignant: Kouassi Clément KOUASSI